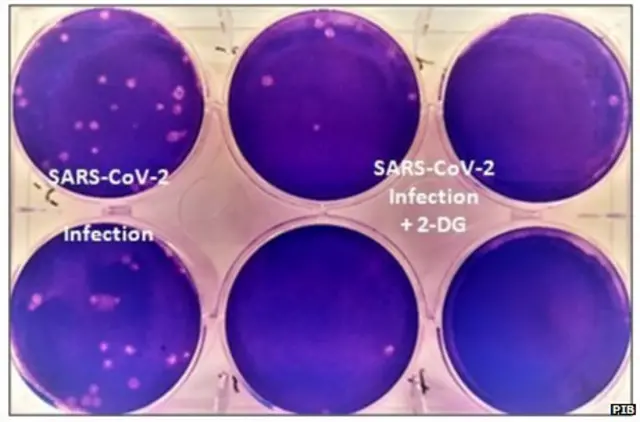
2 डीऑक्सी - डी- ग्लूकोज

कोरोना : जानिए 'ऑक्सीजन संकट' से निपटने में कैसे काम आएगी नई 2-DG दवा?

इमेज स्रोत, Getty Images
- Author, सरोज सिंह
- पदनाम, बीबीसी संवाददाता, दिल्ली
- पढ़ने का समय: 7 मिनट
भारत में कोरोना की दूसरी लहर के बीच सबसे ज़्यादा दिक़्क़त ऑक्सीजन को लेकर सामने आ रही है. दिल्ली समेत देश के दूसरे राज्यों में अस्पतालों में समय पर ऑक्सीजन ना मिलने से हुई मौतें किसी से छुपी नहीं है. पिछले एक हफ़्ते से लगातार कोर्ट में ऑक्सीजन संकट पर सुनवाई चल रही है.
इन सबके बीच एक ख़बर ये आई है कि भारत सरकार ने एक ऐसे एंटी कोविड ड्रग को मंज़ूरी दी है, जो ऑक्सीजन पर कोविड 19 के मरीज़ की निर्भरता को कम करता है.
ड्रग का नाम है 2 डीऑक्सी- डी- ग्लूकोज जिसे शॉर्ट में 2-डीजी भी कहा जा रहा है.
भारत के औषधि महानियंत्रक (डीजीसीआई) ने इसके इमरजेंसी इस्तेमाल को मंज़ूरी दे दी है.
इस लेख में X से मिली सामग्री शामिल है. कुछ भी लोड होने से पहले हम आपकी इजाज़त मांगते हैं क्योंकि उनमें कुकीज़ और दूसरी तकनीकों का इस्तेमाल किया गया हो सकता है. आप स्वीकार करने से पहले X cookie policy और को पढ़ना चाहेंगे. इस सामग्री को देखने के लिए 'अनुमति देंऔर जारी रखें' को चुनें.
पोस्ट X समाप्त, 1
यह दवा रक्षा अनुसंधान एवं विकास संगठन ( डीआरडीओ ) के नाभिकीय औषधि और संबद्ध विज्ञान संस्थान (आईएनएमएएस) ने हैदराबाद स्थित डॉ. रेड्डीज लैब के साथ मिल कर तैयार किया है. तीन चरणों के ट्रायल के बाद इसे मंज़ूरी दी गई है.
यह पूरी तरह से भारत में विकसित पहली एंटी कोविड दवा बताई जा रही है.

इमेज स्रोत, PIB
कब और कहाँ हुए ट्रायल?
कोरोना महामारी की पहली लहर के दौरान ही आईएनएमएएस-डीआरडीओ के वैज्ञानिकों ने पिछले साल अप्रैल के महीने में इस दवा के लैब ट्रायल्स शुरू किए थे. इस काम में डीआरडीओ के वैज्ञानिकों की मदद हैदराबाद के सेंटर फॉर सेलुलर एंड माइक्रो बॉयलॉजी लैब ने की.
उस दौरान पाया गया कि ये 2-डीजी ड्रग कोरोना वायरस के ग्रोथ को रोकने में मददगार साबित हो सकता है.
आईएनएमएएस-डीआरडीओ के दो वैज्ञानिक डॉ. सुधीर चांदना और डॉ. अनंत भट्ट ने इस पर काम किया.
बीबीसी पंजाबी के सहयोगी पत्रकार सत सिंह से बातचीत में डॉ. सुधीर चांदना ने बताया, "पिछले साल जब देश में पूर्ण लॉकडाउन लगा था, उस वक़्त हैदराबाद जा कर डॉ. अनंत ने इसपर लैब एक्सपेरिमेंट किए. इससे पहले भी डीआरडीओ की लैब में इस ड्रग का इस्तेमाल दूसरी बीमारियों के क्लीनिकल ट्रायल में किया गया था. हमने ब्रेन ट्यूमर के मरीज़ो की रेडियो थेरेपी में इसका इस्तेमाल किया फिर फेज़ थ्री के ट्रायल के लिए डॉ. रेड्डीज को टेक्नोलॉजी ट्रांसफ़र की गई."
डॉ. चांदना आईएनएमएएस-डीआरडीओ के रेडिएशन बॉयोसाइंस विभाग के हेड के तौर पर इस समय काम करे रहे हैं. पहले चरण के लैब ट्रायल्स के नतीजों के आधार पर ड्रग कंट्रोलर जनरल ऑफ इंडिया ने फेज़ 2 ट्रायल को मंजूरी दी, जो साल 2020 में मई के महीने में ही शुरू कर दिए गए .
दूसरे चरण में आईएनएमएएस-डीआरडीओ ने हैदराबाद के डॉ. रेड्डीज लैब के साथ मिल कर ट्रायल किए. छह महीने तक चले इन ट्रायल्स के बाद पता चला कि कोविड 19 मरीज़ों की जल्द रिकवरी में ये दवा काफ़ी मददगार साबित हो सकती है. इस ड्रग का ट्रायल दूसरे चरण में 17 अस्पतालों में 110 मरीज़ों पर किया गया था.

इमेज स्रोत, PIB
ट्रायल के नतीजे
फेज़ 2 ट्रायल के नतीज़ों के बारे में बीबीसी से बात करते हुए डॉ. चांदना ने बताया, "नतीज़ों में पाया गया कि स्टैंडर्ड उपचार के साथ 2 डीजी ड्रग के इस्तेमाल के बाद कोविड 19 के मरीज़ औसतन दो से तीन दिन पहले ठीक होते नज़र आए."
इन नतीजों के आधार पर डीजीसीआई ने फेज़ 3 ट्रायल के लिए नवंबर 2020 को मंज़ूरी दे दी.
दिसंबर 2020 से मार्च 2021 तक तीसरे चरण के ट्रायल देश के अलग-अलग शहरों के 27 अस्पतालों में 220 मरीज़ो पर किए गए. ये अस्पताल दिल्ली, उत्तर प्रदेश, पश्चिम बंगाल, महाराष्ट्र, आंध्र प्रदेश, तेलंगाना, कर्नाटक और तमिलनाडु जैसे राज्यों में थे.
डॉ. चांदना का दावा है, "फेज़ 3 ट्रायल के नतीजों में पाया गया कि कोविड 19 मरीज़ो के लक्षण में तेजी से सुधार हुए और 42 फ़ीसदी मरीज़ जिन्हें स्टैंडर्ड केयर के साथ-साथ ड्रग 2-डीजी दिया गया, तीसरे दिन ही उनकी ऑक्सीजन पर निर्भरता भी कम हो गई.
65 से अधिक उम्र के मरीज़ों में भी ऐसा ही ट्रेंड देखने को मिला.
दरअसल जिन मरीज़ों पर फेज़ 3 में ट्रायल्स किए गए, वो सब ऑक्सीजन पर निर्भर थे. जबकि जिन मरीजों को केवल स्टैंडर्ड केयर में रखा गया उनमें केवल 31 फ़ीसदी की ही ऑक्सीजन पर निर्भरता कम हुई."
यानी फेज़ 2 और फेज़ 3 के ट्रायल्स क्रमश: 110 और 220 मरीज़ों पर हुए. इस दवा के इस्तेमाल पर पाए गए नतीज़ों के आधार पर ही सरकार ने कोविड19 के मरीज़ों के इस्तेमाल के लिए इसे मंज़ूरी दे दी.
एक नज़र में देखें तो भारत जैसे बड़ी जनसंख्या वाले देश के लिए क्या इतना छोटा सैम्पल साइज़ सही था?
इस लेख में X से मिली सामग्री शामिल है. कुछ भी लोड होने से पहले हम आपकी इजाज़त मांगते हैं क्योंकि उनमें कुकीज़ और दूसरी तकनीकों का इस्तेमाल किया गया हो सकता है. आप स्वीकार करने से पहले X cookie policy और को पढ़ना चाहेंगे. इस सामग्री को देखने के लिए 'अनुमति देंऔर जारी रखें' को चुनें.
पोस्ट X समाप्त, 2
इस सवाल पर डॉ. चांदना कहते हैं कि फेज़ 2 ट्रायल के नतीज़े इतने ठोस थे कि फेज़ 3 में ज़्यादा लोगों पर ट्रायल की ज़रूरत ही नहीं थी.
इसके बाद डीजीसीआई से इसके कोविड19 के मरीज़ों के इस्तेमाल पर मंज़ूरी के लिए आवेदन किया गया. 1 मई 2021 को कोविड19 के दवा के तौर पर इसके इमरजेंसी इस्तेमाल की सरकार से मंज़ूरी मिल गई है.
इमेज स्रोत, PIB
हालांकि सोशल मीडिया पर इस तरह के पोस्ट भी देखने को मिल जाएंगे, जिसमें दावा किया जा रहा है कि इस दिशा में पहल पंतजिल ने की थी.
इस लेख में X से मिली सामग्री शामिल है. कुछ भी लोड होने से पहले हम आपकी इजाज़त मांगते हैं क्योंकि उनमें कुकीज़ और दूसरी तकनीकों का इस्तेमाल किया गया हो सकता है. आप स्वीकार करने से पहले X cookie policy और को पढ़ना चाहेंगे. इस सामग्री को देखने के लिए 'अनुमति देंऔर जारी रखें' को चुनें.
पोस्ट X समाप्त, 3
इस लेख में X से मिली सामग्री शामिल है. कुछ भी लोड होने से पहले हम आपकी इजाज़त मांगते हैं क्योंकि उनमें कुकीज़ और दूसरी तकनीकों का इस्तेमाल किया गया हो सकता है. आप स्वीकार करने से पहले X cookie policy और को पढ़ना चाहेंगे. इस सामग्री को देखने के लिए 'अनुमति देंऔर जारी रखें' को चुनें.
पोस्ट X समाप्त, 4
कैसे काम करती है ये दवा?
चूंकि कोरोना वायरस से संक्रमित मरीज़ों की हालात ऑक्सीजन लेवल के कम होने के साथ बिगड़ती चली जाती है, इस वजह से इस एंटी कोविड ड्रग 2-डीजी को कोरोना के इलाज में रामबाण माना जा रहा है.
डॉ. चांदना कहते हैं, "इस ड्रग की ख़ासियत ये है कि अगर कोई वायरस शरीर में दूसरी कोशिकाओं को संक्रमित कर रहा होता है तो ये पता लगा कर उन वायरस में ही जाता है, जो संक्रमण का कारण होते हैं.
शरीर के अदर ये ड्रग ऐसे ही जाता है जैसे ग्लूकोज़. संक्रमित कोशिकाओं के अंदर जा कर एनर्जी को कम कर देता है, जिस वजह से संक्रमण का प्रसार या ग्रोथ नहीं हो पाता और मरीज़ के ऑक्सीजन स्पोर्ट की ज़रूरत धीरे-धीरे नहीं पड़ती."

इमेज स्रोत, Reuters
डॉ. चांदना कहते हैं कि ये ड्रग फेफड़ों में पहुँच कर भी ऐसे ही काम करते हैं. लेकिन इसके ठोस सबूत के लिए और स्टडी की जा सकती है.
किन पर इस्तेमाल हो सकती है दवा?
डॉ. चांदना के मुताबिक़ अस्पताल में भर्ती मॉडरेट से सीवियर मरीज़ों पर ही इसका इस्तेमाल किया जा सकता है. ऐसे मरीज़ जो ऑक्सीजन स्पोर्ट पर अस्पतालों में या दूसरी केयर यूनिट में भर्ती है, उन्हीं पर ट्रायल के दौरान इसका ज़्यादा असर देखने को मिला है.
कब से मिलने लगेगी दवा?
ये ड्रग ग्लूकोज़ का ही एनालॉग है और जेनेरिक मॉलिक्यूल है. इस वजह से इसके बनने और उपलब्धता को लेकर भारत सरकार आश्वस्त हैं.
ये ड्रग पॉउडर के रूप में आएगी, जिसे पानी में घोल कर इस्तेमाल किया जा सकेगा, जैसे ग्लूकोज़ का इस्तेमाल करते हैं.
हालांकि भारतीय बाजार में इसकी उपलब्धता डॉ. रेड्डीज लैब पर निर्भर करती है. डीआरडीओ की ट्रायल प्रक्रिया में डॉ. रेड्डीज लैब ही उनके इंडस्ट्री पार्टनर थे.
बीबीसी ने डॉ. रेड्डीज लैब से इस बारे में संपर्क किया, लेकिन इस पर कोई जवाब नहीं आया है.
इस पूरी प्रक्रिया में डॉ. चांदना के साथ जुड़े रहे डीआरडीओ के दूसरे वैज्ञानिक डॉ. अंनत भट्ट ने बीबीसी को बताया, सोमवार देर शाम तक इसके टाइमलाइन की विस्तृत सूचना जारी की जा सकती है. लेकिन हर हाल में 3-4 हफ़्ते का समय लग जाएगा.

डोज़ और क़ीमत
हालांकि डॉ. चांदना ने इतना ज़रूर बताया कि कोविड 19 के मरीज़ की हालात को देखते हुए इसके पाँच से सात दिन के डोज की ज़रूरत पड़ेगी. बिना डॉक्टरों की सुपरविजन और प्रिस्क्रिपशन के घर में रह कर इलाज करा रहे मरीज़ों को ये दवा नहीं दी जा सकेगी.
लेकिन एक पैकेट की कीमत कितनी होगी, इसके बारे में फ़िलहाल कोई जानकारी उपलब्ध नहीं है.
हालांकि डॉ. अनंत भट्ट ने बीबीसी को बताया कि इस ड्रग को बनाने में इस्तेमाल होने वाले कच्चे माल की क़ीमत प्रति डोज़ 500-600 रुपए है. यानी 5 डोज़ में इस्तेमाल होने वाले कच्चे माल की कीमत 2500 से 3000 रुपए के बीच होगी.
इस आधार पर ड्रग के दाम का एक अंदाजा भर लगाया जा सकता है, लेकिन बड़ी मात्रा में प्रोडक्शन होने पर ये दाम कम हो भी सकते हैं.
ड्रग की क़ीमत पर अंतिम फ़ैसला डॉ. रेड्डीज लैब का ही होगा.
2-डीजी का दुनिया भर में इस्तेमाल
ऐसा नहीं कि 2-डीजी पर क्लीनिकल टेस्ट पहली बार किसी वायरस के पर किया गया हो.
लेकिन कोविड 19 महामारी में दुनिया के दूसरे देशों में इसका इस्तेमाल हो रहा है, इस बारे में डीआरडीओ के वैज्ञानिकों को जानकारी नहीं है. उनके मुताबिक़ ये पहला मौका है जब किसी बड़ी महामारी से निजात दिलाने में 2 -डीजी ड्रग के इस्तेमाल की इज़ाजत मिली हो.

2-डीजी के इस्तेमाल पर पाबंदियाँ
एक बात तो स्पष्ट है कि इस ड्रग का इस्तेमाल कोविड 19 के सभी कैटेगरी के मरीज़ नहीं कर सकेंगे.
डॉ. अंनत भट्ट ने बीबीसी से बातचीत में बताया कि ट्रायल प्रक्रिया के दौरन गर्भवती महिलाओं और किडनी के गंभीर मरीज़ों पर इसका इस्तेमाल नहीं किया गया था.
हालाँकि आईसीएमआर इस बारे में डॉक्टरों के साथ मिल कर और तीन चरणों के नतीजों के आधार पर जल्द ही विस्तृत गाइडलाइन जारी करेगा. लेकिन इतना तय है कि किडनी के गंभीर मरीज़ों और गर्भवती महिलाओं पर ये नहीं इस्तेमाल की जा सकेगी.
यानी दूसरी लहर में कोरोना संक्रमित मरीज़ों पर इसके इस्तेमाल में अभी कुछ और दिन इंतज़ार करना होगा.
ये भी पढ़ें :
(बीबीसी हिन्दी के एंड्रॉएड ऐप के लिए आप यहां क्लिक कर सकते हैं. आप हमें फ़ेसबुक और ट्विटर पर फ़ॉलो भी कर सकते हैं.)














